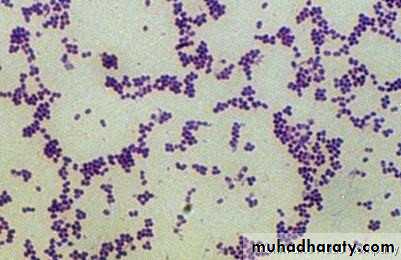

Microbiology
Toxonomy &Cell StructureWhat is Microbiology
Microbiology :Is The branch of biology that deals with microorganisms and their effects on other living organisms. Microorganisms are those organisms that are too small to see with the naked eye and include things like bacteria, fungi, and viruses.
Microbiology is Greek word mikros mean small; bios mean life
• Current classification of all forms of life based on the genetic relatedness into 3 domains :
• Archea
• ,Bacteria
• Eucarya
• Archea and Bacteria called Prokaryotes
• Eukaryotes (Fugi , protista ,animal, plant and human)
• Prokaryotic Cells
Viruses
are not included in this classification as they are unique , metabolically inert organisms and therefore replicate only within living cells.• Cell component
ProkaryotesEukaryotes
Nucleus
no membrane, single circular chromosome
membrane bound, a number of individual chromosomes.
Extra-chromosomal DNA
present in form of plasmid
Present as mitochondrial DNA
Organelles in cytoplasm
Non
Mitochondria and chloroplast in photosynthetic organisms
Cytoplasmic membrane
Contain enzyme of respiration, sit of phospholipids and DNA synthesis
Semi-permeable layer not possessing function
Cell wall
Rigid layer of peptidoglycan
No peptidoglycan
Sterols
Absent
Present
Ribosome
70 S in cytoplasm
80 S in cytoplasmic reticulum
• Basis of Classification
Phenotypic classification• Morphological
• Anatomical
• Staining
• Cultural characteristics
• Nutrition
• Environmental factors
• Biochemical reactions
• Antigenic structure
Genotypic classification
• DNA-DNA hybridization
• G+C content
Bacteria can be classified into six major groups on morphological basis.
1. TRUE BACTERIACocci – These are spherical or oval cells. On the basis of arrangement of individual organisms they can be described as
Monococci (Cocci in singles) – Monococcus spp.
Diplococci (Cocci in pairs) – Streptococcus pneumoniae
Staphylococci (Cocci in grape-like clusters) – Staphylococcus aureus
Streptococci (Cocci in chains) – Streptococcus pyogenes
Tetrad (Cocci in group of four) - Micrococcus spp.
Sarcina (Cocci in group of eight)
Morphological classification
Streptococcus
• Staphylococcus
tetrad• Morphological classification
Bacilli – These are rod-shaped bacteria. On the basis of arrangement of organisms, they can be described asDiplobacilli
Streptobacilli
Palisades
Chinese-letter form
Coccobacilli
Comma-shaped
bacilli
•Coryneform bacteria
bifidobacteriumvibrio cholerae
Morphological classification
2. ACTINOMYCETES (actin- ray, mykes-fungus)These are rigid organisms like true bacteria but they resemble fungi in that they exhibit branching and tend to form filaments.
They are termed such because of their resemblance to sun rays when seen in tissue sections.
Morphological classification
3. SpirochaetesThese are relatively longer, slender, non-branched microorganisms of spiral shape having several coils.
4. Mycoplasmas
These bacteria lack in rigid cell wall (cell wall lacking) and are highly pleomorphic and of indefinite shape.
They occur in round or oval bodies and in interlacing filaments.
5. Rickettsiae and Chlamydiae
These are very small, obligate parasites, and at one time were considered closely related to the viruses. Now, these are regarded as bacteria.Morphological classification
CapsuleCapsulate– Streptococcus pneumoniae
Non-capsulate – Viridans streptococci
Flagella
Flagellate –
Monotrichous
Lophotrichous
Amphitrichous
Peritrichous
Aflagellate – Shigella spp.
Spore
Spore-forming – Bacillus spp.
Non-sporing – Escherichia coli
Based on Staining reaction
GRAM’S STAINGram-positive cocci – Staphylococcus aureus
Gram-negative cocci – Neisseria gonorrhoeae
Gram-positive rods – Clostridium spp.
Gram-negative rods – E. coli
ACID FAST STAIN
Acid-fast bacilli –Mycobacterium tuberculosisNon-acid-fast bacilli – Staphylococcus aureus
Extra growth factors requirements
Fastidious – Hemophilus influenzaeNon-fastidious – Escherichia coli
Hemolysis on Sheep Blood Agar
Alpha-hemolysis – Streptococcus pneumoniaeBeta-hemolysis – Streptococcus pyogenes
Utilization of carbohydrates
Oxidative - Micrococcus
Fermentative – Escherichia coli
Based on Cultural characteristics
Growth rateRapid growers– Vibrio cholerae
Slow growers – Mycobacterium tuberculosis
Pigment production
Pigment producer – Staphylococcus aureusPigment non-producer – Escherichia coli
Based on Cultural characteristics
Based on NutritionAutotrophs
Heterotrophs
Temperature
Oxygen dependencepH
Salt concentration
Atmospheric pressure
Based on environmental factors
Based on environmental factors
• TemperaturePsychrophiles (15-200C) – Pseudomonas fluorescens
Mesophiles (20-400C) – Escherichia coli, Salmonella enterica, Staphylococcus aureusThermophiles (50-600C)- Bacillus stearothermophilus
Extremely thermophiles (as high as 2500C) -ArcheaBased on environmental factors
• 2. Oxygen dependenceAerobe (grow in ambient temperature, which contains 21% O2 and a small amount of CO2, 0.03%)
Obligate aerobes – Strictly require O2 for their growth (Pseudomonas aeruginosa)
Microaerophilic (grow under reduced O2, 5-10% and increased CO2, 8-10%)- Campylobacter jejuni, Helicobacter pyloriBased on environmental factors
• 2. Oxygen dependence
Facultative anaerobe (capable of growing either in presence or absence of O2)- E. coli
Obligate anaerobe – Clostridium spp.
Capnophilic (require increased concentration of CO2, i.e., 5-10%) –
H. influenzae,
N. gonorrhoeae
Aerotolerant
Based on environmental factors
• 3. pHAcidophiles (Lactobacillus acidophilus)
Alkaliphiles (Vibrio)Neutralophiles (pH 6-8)
Majority of the medically important bacteria grow best at neutral or slightly alkaline reaction (pH 7.2-7.6)
4. Salt concentration
HalophilesNon-halophiles
Based on environmental factorsOther ways of classification
Motile/Non-motilePathogenic/Non-pathogenic
Sensitive/Resistant (to particular antibiotic/ chemicals)
Lactose fermenter/Lactose non-fermenter
Bergey’s Manual of Determinative Bacteriology
Gram-negative eubacteria that have cell walls
Gram-positive eubacteria that have cell walls
Cell wall-less eubacteria: Mycoplasma
Archaeobacteria
Structure
Structures external to the cell wall
• Flagella
Flagella are whip-like filaments that act as propellers and guide the bacteria towards nutritional and other sources. Composed of single protein called Flagellin.
Type of Flagellum
Flagella may belocated at one end Monotrichous
a single flagellum Lophotrichous
All over the outer surface Peritrichous
Located at the polar ends Amphitrichous
Fimbriae and pili
1-are fine, hair-like filaments, shorter than flagella, that extend from the cell surface.2- Pili found mainly on Gram-negative organisms
3- Composed of subunits protein, pilin.
4- mediate the adhesion of bacteria to receptors on the human cell surface – a necessary first step in the initiation of infection..
A specialized type of pilus,
the sex pilus, forms the attachment between the male (donor) and the female (recipient) bacteria during conjugation, when genes are transferred from one bacterium to another.THE STRUCTURES EXTERNAL TO THE CELL WALL
AXIAL FILAMENTSAnchored at one end of the spirochete.
Have a structure similar to flagella.
Filament rotation produces a movement of the outer sheath. Propels the bacteria in a spiral motion (corkscrew motion).
E.g. Treponema pallidum – syphilis
Borrelia burgdorferi – Lyme disease
Glycocalyx (slime layer)
1- is a polysaccharide2-coating that covers the outer surfaces of many bacteria
3-allows the bacteria to adhere frmly to various structures, e.g. oral mucosa, teeth,heart valves and catheters.
4-contribute to the formation of bioflms.
This is especially true in the case of Streptococcus mutansCapsule
1-An amorphous, gelatinous layer (usually more substantial than the glycocalyx) surrounds the entire bacterium.2- it is composed of polysaccharide, and sometimes protein (e.g.anthrax bacillus).
The capsule is important
• It mediates the adhesion of bacteria to human tissues or prosthesis such as dentures or implants prerequisitecolonization and infection.
It hinders or inhibits phagocytosis; hence, the presence of a capsule correlates with virulence.
The capsule is important
It helps in laboratory identifcation of organisms (inthe presence of antiserum against the capsular polysaccharide the capsule will swell greatly – a phenomenon called the quelling reaction).
Its polysaccharides are used as antigens in certain vaccines because they elicit protective antibodies (e.g. polysaccharide vaccine of S. pneumoniae
THE CELL WALL
Cell wall – a complex, semirigid structureProtects cell from adverse changes in the outside environment.
Almost all prokaryotes have cell walls.
Major function is to prevent bacterial cells from rupturing.
Maintain the shape of the bacterium.
Serve as point of anchorage for flagella.
THE CELL WALL
Contributes to PathogenecitySite of action of some antibiotics.
Cell wall composition used to differentiate major types of bacteria.
Cell Wall In Gram positive bacteria
Peptidoglycan layer forms 50% of cell wall material.Peptidoglycan is responsible for cell wall rigidity.
Peptidoglycan is formed of N-acetyl glucosamine and N-acetyl muramic acid.
Attached to each muramic acid molecule is a tetrapeptide.
Then the tetrapeptide chains are cross-linked together by transpeptidase enzyme.
In addition to peptidoglycan, there isteichoic acid which:
is highly immunogenic adheres the bacteria to mucosal surfaces.
Lipoteichoic acid links peptidoglycan layer to the cell membrane.
Gram-negative organisms
Inner peptidoglycan layer forms only 5-10% of the cell wall material.Outer membrane layer formed of lipopolysaccharides:
The lipid portion (lipid A) is called endotoxin. It is released when the bacterial cells are lysed. It is highly toxic.
The polysaccharide portion is called somatic or O antigen. It is highly immunogenic.
The space between the inner and outer layers is called periplasmic space which contains beta lactamase enzyme that degrades beta lactam antibiotics.
Lipoprotein molecules cross-link the peptidoglycan layer and the outer membrane
Grame Negative Cell
Gram Positive Cell3 Layers
1-Inner cytoplasmic membrane
2- Thin peptidoglycan layer (5-10%)
3-Outer membrane with Lipopolysaccharide(LPS)
2 Layers
1-Inner cytoplasmic membrane
2-Outer thick peptidoglycan layer (60-100%)
High lipid content
Low lipid content
Endotoxine(LPS). Lipid A
No endotoxine (except Listeria monocytogenes)
periplasmic space
No periplasmic space
porin channel
No porin channel
Resistto Lysozyme and penicillin attack
Virulence to Lysozyme and penicillin attack
In acid fast bacteria
These bacteria contain high concentration of mycolic acid and wax in their cell wall.
These bacteria are not stained by Gram stain but stained by Ziehl-Neelsen stain.
Example: Mycobacterium tuberculosis.
Bacteria with defective cell walls
Mycoplasma sppLacks cell wall.
Pleomorphic in shape.
Not affected by penicillin.
Not stained by Gram stain.
The only bacteria that contains sterol in its cell membrane.
Protoplast , Spheroplast, L-Form
When bacterial cell wall is lost under the effect of certain conditions like penicillin:Gram positive bacteria form protoplasts.
Gram negative bacteria form spheroplasts.
If protoplasts and spheroplasts grow and divide, they are called L-forms.
Unlike mycoplasma, L-forms can revert to the parental form on removal of the cell wall inhibitor.
Cytoplasmic membrane
The cytoplasmic membrane lies just inside the peptidoglycan layer of the cell wall and is a ‘unit membrane’ composed of a phospholipid bilayer similar in appearance to that of eukaryotic cells. However, eukaryotic membranes contain sterols, whereas prokaryotes generally do not (the only
exception being mycoplasmas.
The membrane has the following major functions
active transport and selective diffusion of molecules and solutes in and out of the cell.• electron transport and oxidativephosphorylation in aerobic specie.
• synthesis of cell wall precursors
• secretion of enzymes and toxins
• supporting the receptors and other proteins of
The chemotactic and sensory transduction systems
Mesosome
This is a convoluted invagination of the cytoplasmic membrane that functions as the origin of the transverse septum that divides the cell in half during cell division.It is also the binding site of the DNA that will become the genetic material of each daughter cel
Cytoplasm
The cytoplasm comprises an inner, nucleoid region (composed of DNA), which is surrounded by an amorphous matrix that contains ribosomes, nutrient granules, metabolites and various ions.Nuclear material or nucleoid
Bacterial DNA comprises a single, supercoiled, circular chromosome that contains about 2000 genes(It is analogous to a single, haploid chromosome.)During cell division, it undergoes semiconservative replication bidirectionally from a fixed point.
Electron micrograph of a thin section of Neisseria gonorrhoeae showing the organizational features of prokaryotic cells. Note the electron-transparent nuclear region (n) packed with DNA fibrils, the dense distribution of ribosomal particles in the cytoplasm, and the absence of intracellular membranous organelles
Ribosomes
Ribosomes are the sites of protein synthesis. Bacterial ribosomes differ from those of eukaryotic cells in both size and chemical composition.They are organized in units of 70S, compared with eukaryotic ribosomes of 80S. These differences are the basis of the selective action of some antibiotics
that inhibit bacterial, but not human.
Cytoplasmic inclusion granules
The cytoplasm contains different types of inclusions, which serve as sources of stored energy; examples include polymetaphosphate, polysaccharide and β-hydroxybutyrate.Bacterial spore
Spores are formed in response to adverse conditions by the medically important bacteriathat belong to the genus
Bacillus (which includes the agent of B.anthrax) and Clostridium (which includes the agents of
Cl. tetanus and CL.botulism).
These bacteria sporulate (form spores) when nutrients, such as sources of carbon and nitrogen, are scarce